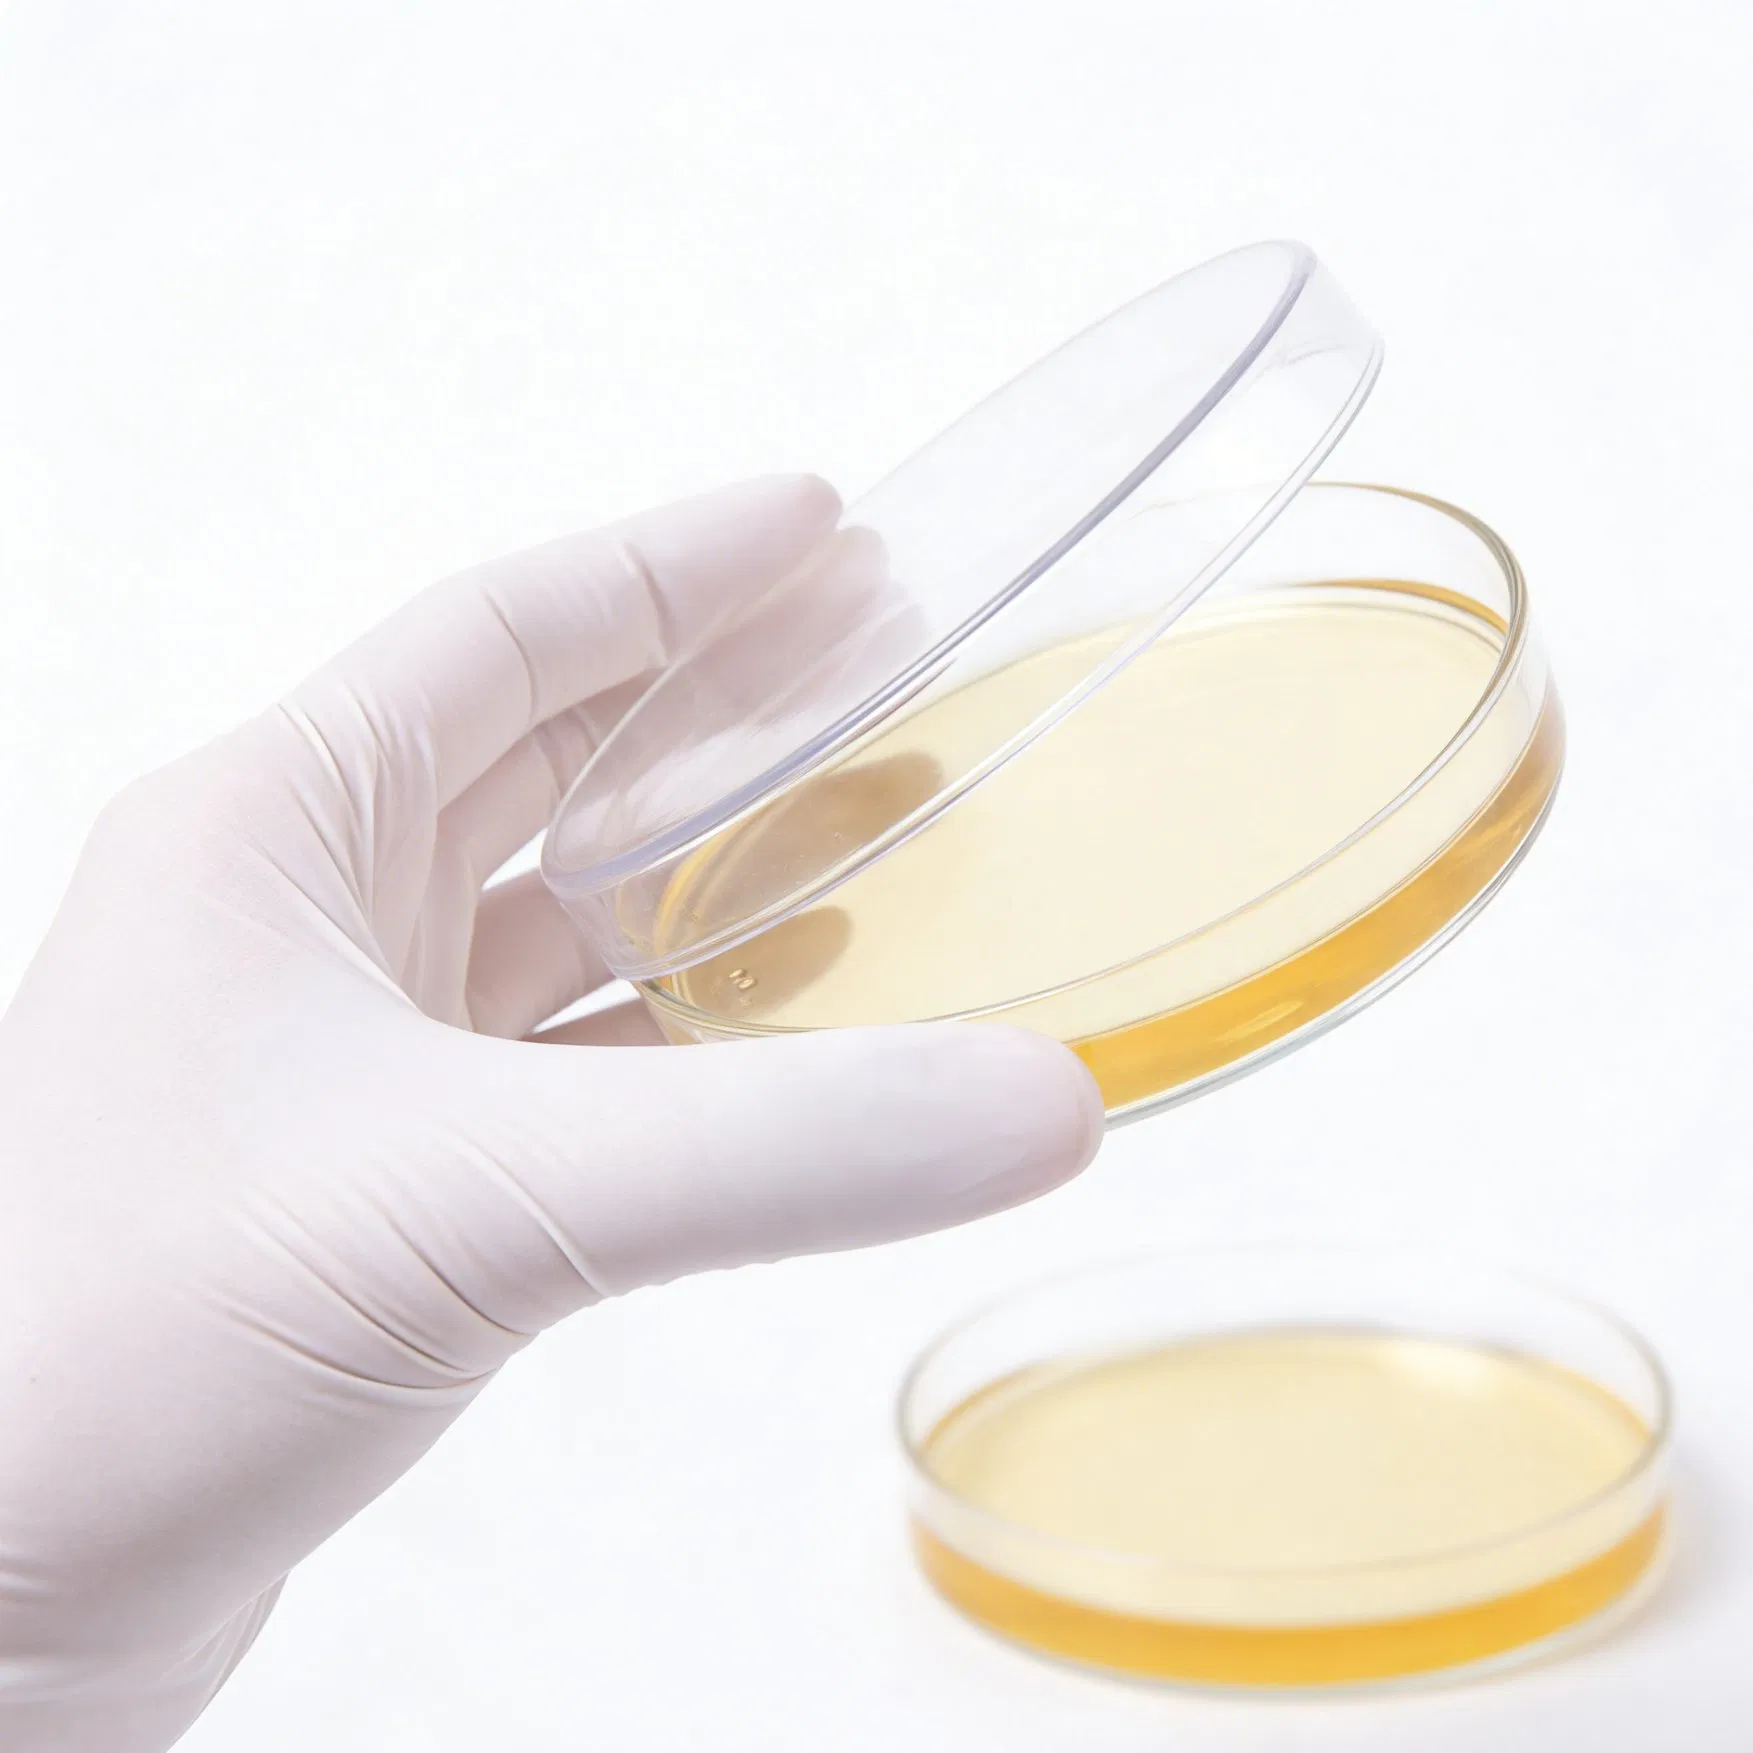
Lab Handling Synthetic White Vinyl Disposable Latex-Free Chemical-Resistant Vinyl Gloves

1 / 5
 Mahesh Medical
Mahesh Medical

| Model NO. | XS S M L XL XXL |
|---|---|
| Certificates | ISO13485 / ISO9001 / EN455 / EN374 |
| Length | 230mm / 240mm / 280mm |
| Surface | Smooth / Textured |
| Latex Free | Yes |
| Food Safe | Yes |
| Ambidextrous | Yes |
| Single Use | Yes |
| Non Sterile | Yes |
| Production Capacity | 2,000,000,000 PCS / Month |

| Material | PVC (Polyvinyl Chloride) |
|---|---|
| Design | Ambidextrous, Non-sterile, Beaded cuff |
| Finish | Powder Free and Powdered available |
| Width (+/- 10mm) | S: 85mm | M: 95mm | L: 105mm | XL: 115mm |
| Applications | Food Processing, Healthcare, Laboratory, Janitorial |












A: We are a professional manufacturer specializing in medical consumables with large-scale production facilities in China.
A: Yes, we provide comprehensive OEM and ODM services to help you build your own brand identity.
A: Absolutely. We offer free samples so you can verify the quality and fit before placing a bulk order.
A: Customized orders generally take 20 to 30 days once the deposit is received and artwork is finalized.
A: Yes, these PVC gloves are 100% latex-free, making them a safe alternative for individuals with Type I latex allergies.
A: Our products are fully certified with ISO13485, ISO9001, EN455, and EN374 to meet international safety and quality standards.